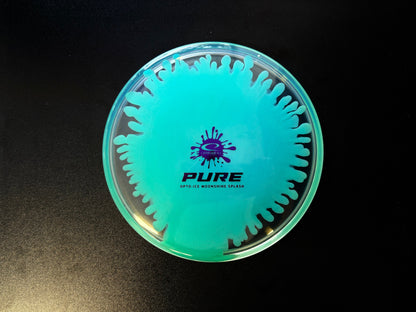

1
/
of
2
Opto-Ice Moonshine Splash Pure
Opto-Ice Moonshine Splash Pure
Regular price
$24.99 USD
Regular price
Sale price
$24.99 USD
Unit price
/
per
Couldn't load pickup availability
Latitude 64
5 | 6 | -1 | 0
Share